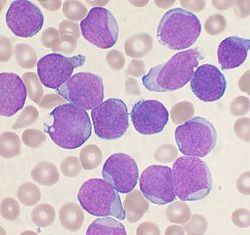

Farmaco reduce la grasa mediante el bloqueo de vasos sanguíneos
Los investigadores han sabido por mucho tiempo que los tumores cancerosos crean colecciones de células sanguíneas anormales, el combustible que alimenta a esta enfermedad...
¿Que es un día extraordinario para una enfermera?
Se pidió a un pequeño grupo de enfermeras con experiencia para describir las características de un día extraordinario en el trabajo. La respuesta universal...
La metástasis en las células madre en la sangre de los...
Las células cancerosas individuales que se desprenden del tumor original y circulan por el torrente sanguíneo y se consideran responsables del desarrollo de metástasis....
OMS dice que la nueva gripe aviar en China no se...
No hay evidencia de que la nueva cepa de la gripe aviar se propague fácilmente entre personas a pesar de que algunos de los...
Un estudio señala que es necesarios regular los suplementos dietéticos
Los suplementos dietéticos representaron más de la mitad de los medicamentos retirados del mercado de Clase 1 por la FDA entre 2004 y 2012,...
Terapia de combinación de fármacos desarrollada para tratar la leucemia
Un nuevo estudio, pre-clínico de investigadores de la Commonwealth University Cancer Center Massey sugiere que una combinación de nuevos fármacos puede conducir a la...
Investigadores identifican y bloquean proteína que interfiere con la hormona que...
La hormona de la regulación del apetito - llamada leptina - fue descubierta en 1994, los científicos han tratado de entender los mecanismos que...
El tratamiento para el nuevo coronavirus muestra promesa en pruebas de...
Científicos de los Institutos Nacionales de Salud (NIH), el estudio de un coronavirus han descubierto una combinación de dos medicamentos antivirales autorizados, ribavirina e...
Periodontitis: El peligro subestimado
De acuerdo con información de la Organización Mundial de la Salud (OMS), la periodontitis es una de las enfermedades más frecuentes y comunes en...
Es un defecto genético lo que provoca la epilepsia
Investigadores del Departamento de Neurología de la Universidad de Viena en el MedUni han identificado un gen detrás de un síndrome de epilepsia, lo...
Vacunación contra el VPH propociona una protección aún mayor en el...
En la actualidad se conocen más de cien cepas del virus del papiloma humano (VPH), catorce de los cuales puede desencadenar el cáncer. Las...
Nuevo virus H7N9 resulta ser una mezcla de tres cepas de...
Hasta ahora desconocido entre los humanos, el nuevo virus es inestable y continúa evolucionando, revela el análisis de los datos genéticos disponibles.
La nueva cepa...